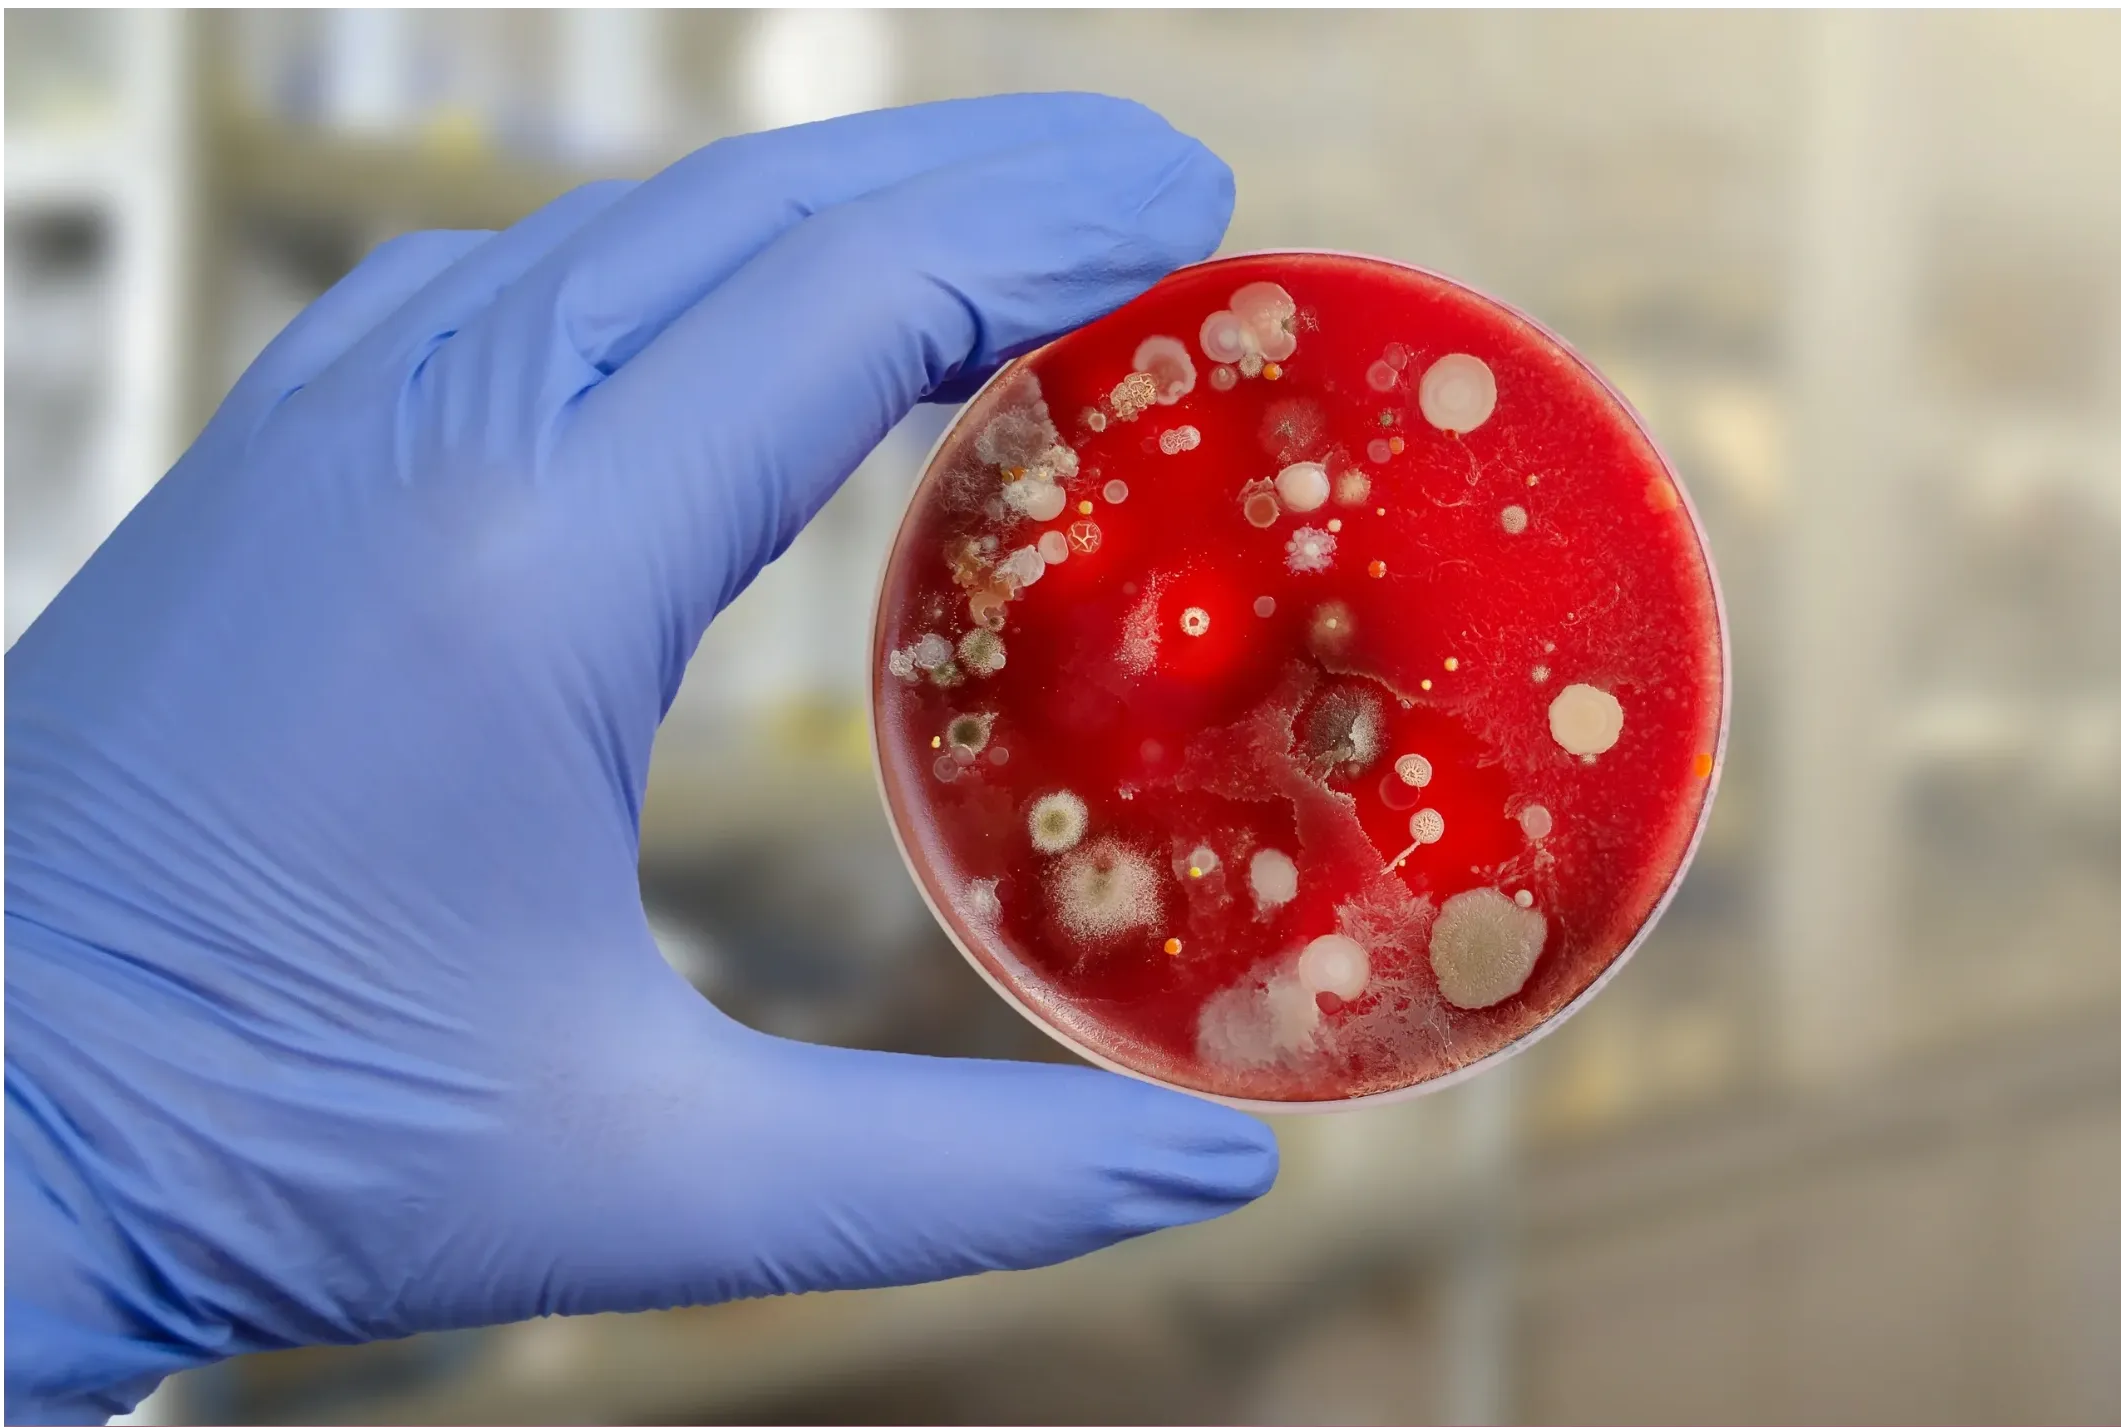

Why Mold Sampling is Pointless
Welcome to Mold Truth, your Environmental Consulting Partner
-
NO SCIENCE:
-
Since NO EPA or other FEDERAL limits have been set for mold or mold spores. Therefore sampling cannot be used to check a building’s compliance with federal mold standards.
-
This statement is confusing to most people because they believe mold sampling is an actual approved procedure by the EPA, and the sampling company’s claiming it’s real do not Properly clarify that they are not licensed or certified from the state licensed.
-
Sampling for mold should NOT be used for any recommendations when remediating mold or water. Mold sample companies state this in their small print.
-
WHAT IS SAMPLING USED FOR?
-
NO APPROVED INSTRUMENTS:
-
Are there federal regulations or standards regarding mold testing?
Read the publication “Mold Remediation in Schools and Commercial Buildings [EPA 402-K-01-001, March 2001]